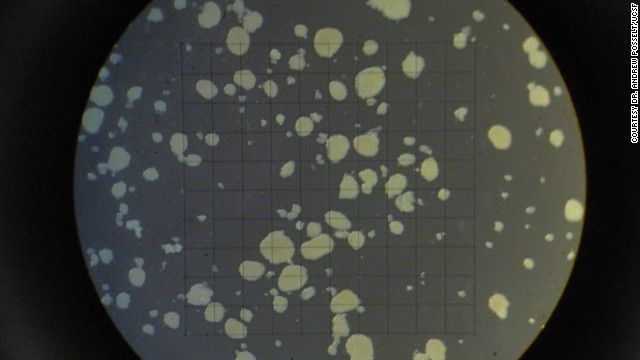

The e-mail ended with a question that belied the author's pain: "It's a small world, isn't it?"
The e-mail ended with a question that belied the author's pain: "It's a small world, isn't it?"
Michael Schofield read the message from Elizabeth Baptiste again. Baptiste worked at AT&T, just like him. She had three sons, like him. And her youngest, Michael, was the donor who had changed his life.
"It sent shivers down my body, you know, because you don't expect..."
Schofield's voice, with its lingering Liverpool accent, trails off.
Schofield, 53, was diagnosed with Type 1 diabetes in 1982. People who have Type 1 diabetes do not produce insulin, a hormone the body needs to convert sugar and starches into energy. Their white blood cells attack and destroy the cells that produce insulin in the pancreas.
Like most Type 1 diabetics, Schofield learned to control his diabetes with insulin injections and constant monitoring. But he still experienced hypoglycemic attacks when his blood sugar levels got too low. It was like being in a fog -- one he couldn't escape until someone helped him. If it went on too long, he would lose consciousness.
As he got older, Schofield's body adapted to the extreme lows; so when his blood sugar levels dropped below normal, he didn't experience the typical symptoms. In other words, he didn't know he was in danger until he passed out.
"Over time, your body just starts to break down," he says. "They say (diabetes) is a slow killer, and it is."
Tiny cells offer hope
Pancreas transplants for patients such as Schofield are not typically an option because they are difficult to perform, said Dr. Michael Rickels, associate professor of medicine at University of Pennsylvania. But an experimental procedure using the pancreas' islet cells is being tested at medical centers around the country. If it's approved by the Food and Drug Administration, it could make a difference for patients who are no longer able to successfully manage their diabetes.
Islet cells contain beta cells that produce insulin, as well as alpha cells that produce a hormone called glucagon. Both are used to regulate the body's glucose, or sugar, levels. In the 1990s, scientists in Alberta, Canada, figured out how to isolate these islets from a deceased donor's pancreas and transplant them into the liver of a diabetic patient. The procedure was dubbed the "Edmonton Protocol."
Since then, researchers have been trying to improve the survival rate of the cells during transplantation. Most patients who undergo the procedure now need two infusions of islet cells to maintain normal glucose levels long-term.
Rickels and his colleagues recently published a study in the journal Diabetes detailing a new protocol, which gives the extracted islets three days to "rest" before they're transferred to the living recipient. All of the patients in Rickels' study were able to come off insulin therapy for at least a year after a single transplant.
Data from patients in other countries where the procedure has already been approved shows some patients can stop using insulin for anywhere from five to 10 years, Rickels said.
Schofield had been following the islet cell research since the 1990s. One Saturday morning, after a particularly bad hypoglycemic attack, he decided to fill out a survey to see whether he qualified for a trial funded by the National Institutes of Health. Two days later, he received a message from the UCSF Medical Center in San Francisco.
Schofield flew from his home in Scottsdale, Arizona, to California to learn more about the transplant.
Dr. Andrew Posselt, co-director of the Pancreatic Islet Cell Transplant Program at UCSF, told Schofield that the procedure would take less than two hours and he would be home within two or three days. He would, however, have to remain on immunosuppressant drugs the rest of his life. The drugs prevent the patient's white blood cells from attacking the new islet cells, Posselt explained.
The next year was filled with medical tests. Schofield didn't receive a donor pancreas in time to participate in the government trial. But he discovered his employer health insurance would pay for the experimental transplant. His doctors helped him submit a request to the FDA to get the private procedure approved.
Now all he needed was a donor.
A life cut short
Michael Baptiste was a good kid, his mom, Elizabeth, says. "Growing up, he was my pain in the butt," she remembers with a laugh. "He was my third child. He was the one who gave me the headaches."
He was also a giving person. When his mom took him to the DMV to get his driver's license, he checked the organ donor box without hesitation.
At 23, he was taking responsibility for his life and his family. He was going to school to become an electrician. He worked nights at Home Depot to provide for his 5-year-old daughter, Angelina. He took his mom to Disneyland.
"He was moving up," Elizabeth Baptiste says. "And it was cut short."
On March 25, 2012, Michael Baptiste was goofing off with friends in a restaurant parking lot. He fell out of a car while the driver was doing donuts, and he hit his head. Doctors kept him alive for six days before pronouncing him brain dead.
A few days later Schofield, received his first infusion of islet cells. Two weeks later, he was off insulin. He looked down at his glucose monitor one day and saw a flat line for the first time in 30 years.
"That was euphoria," he says. He still wears his monitor to this day, enjoying the high looking at the flat line gives him.
Schofield sent a note to his anonymous donor's family, thanking them for giving him a second chance at life. He then began speaking publicly about his transplant, urging the FDA to approve the procedure for others in the United States.
"People need to be aware that this is an effective alternative treatment," Posselt said. "Funding is very difficult to get for this kind of procedure in the U.S.; as a result, we're falling behind other countries."
Two human clinical trials are underway in the United States. Once both are completed, researchers will submit the data to the FDA for review. Rickels hopes in the next two to three years, all his and his colleagues' hard work will pay off.
Only about 5% of people with diabetes have Type 1, according to the American Diabetes Association. Islet cell transplantation cannot help those with Type 2 diabetes, Posselt said, because they already produce insulin -- their bodies just have a greater resistance to the hormone.
"I think that this procedure can definitely benefit some diabetics, but I don't think it's the panacea for every diabetic," he said.
Saying thank you
On June 1, Schofield met Elizabeth Baptiste at Pier 39 in San Francisco. She wore a Donald Duck T-shirt to represent her son's favorite Disney character. When she saw Schofield, she waved her hand high in the air and had a flashback to the days when she used to do the same for Michael when he ran off in a crowd.
The meeting was a mix of emotions for Schofield.
"It's a happy moment that I got the transplant, got to meet her, say thank you," Schofield remembers. "It's a sad moment because having three children of my own, I can't imagine the pain."
But for Baptiste, it was therapeutic. She hasn't heard from any of her son's other recipients.
"I've told people, 'I know my son is dead,' " she says. "But I know other people have his parts, so I know he's still alive. Michael came to me at the right time. ... I needed a hug from my son, and that's what he was there for."
Source - CNN News


 সম্প্রতি এক গবেষণায় জানা গেছে, কম বয়সে অ্যান্টিবায়োটিক খেলে পরবর্তী ক্ষেত্রে মানব শরীর বিভিন্ন ধরনের রোগ প্রতিরোধ করতে সক্ষম থাকে৷ কলোম্বিয়ার ব্রিটিশ বিশ্ববিদ্যায়লের এ গবেষণা অনুযায়ী, অন্ত্রে বিভিন্ন ধরনের ব্যাকটেরিয়া বিরাজ করে, যা রোগ প্রতিরোধ ক্ষমতা স্বাস্থ্যকর রাখে৷
কিন্তু...
সম্প্রতি এক গবেষণায় জানা গেছে, কম বয়সে অ্যান্টিবায়োটিক খেলে পরবর্তী ক্ষেত্রে মানব শরীর বিভিন্ন ধরনের রোগ প্রতিরোধ করতে সক্ষম থাকে৷ কলোম্বিয়ার ব্রিটিশ বিশ্ববিদ্যায়লের এ গবেষণা অনুযায়ী, অন্ত্রে বিভিন্ন ধরনের ব্যাকটেরিয়া বিরাজ করে, যা রোগ প্রতিরোধ ক্ষমতা স্বাস্থ্যকর রাখে৷
কিন্তু...
 ঢাকা বিশ্ববিদ্যালয়ের ক্লিনিক্যাল সাইকোলজি বিভাগ ও বাংলাদেশ ক্লিনিক্যাল সাইকোলজি সোসাইটির যৌথ উদ্যোগে ‘Mental Health Gap in Bangladesh: Resources and Response’ শীর্ষক চার দিনের চতুর্থ মানসিক স্বাস্থ্যবিষয়ক আন্তর্জাতিক সম্মেলনের উদ্বোধন হয়েছে।
বুধবার ঢাকা...
ঢাকা বিশ্ববিদ্যালয়ের ক্লিনিক্যাল সাইকোলজি বিভাগ ও বাংলাদেশ ক্লিনিক্যাল সাইকোলজি সোসাইটির যৌথ উদ্যোগে ‘Mental Health Gap in Bangladesh: Resources and Response’ শীর্ষক চার দিনের চতুর্থ মানসিক স্বাস্থ্যবিষয়ক আন্তর্জাতিক সম্মেলনের উদ্বোধন হয়েছে।
বুধবার ঢাকা...
.jpg&w=60&h=40&zc=2) অনেক সময় কোনো ওষুধ একটি রোগ সারিয়ে তুললে, সেই ওষুধই অন্য একটি অসুখকে আমন্ত্রণ জানিয়ে রাখে। এমনকি এক্স রে রশ্মিও আমাদের শরীরে ক্যান্সারের মতো মারণ রোগের জন্ম দেয়।
ওষুধের প্রভাবে কী কী পার্শ্বপ্রতিক্রিয়া হতে পারে
১. ওষুধে ডায়াবিটিস বাড়তে পারে: সাধারণত ইনসুলিনের অভাবে ডায়াবিটিস হয়।...
অনেক সময় কোনো ওষুধ একটি রোগ সারিয়ে তুললে, সেই ওষুধই অন্য একটি অসুখকে আমন্ত্রণ জানিয়ে রাখে। এমনকি এক্স রে রশ্মিও আমাদের শরীরে ক্যান্সারের মতো মারণ রোগের জন্ম দেয়।
ওষুধের প্রভাবে কী কী পার্শ্বপ্রতিক্রিয়া হতে পারে
১. ওষুধে ডায়াবিটিস বাড়তে পারে: সাধারণত ইনসুলিনের অভাবে ডায়াবিটিস হয়।...
 চীনের একটি গাছের নাম হর্নি গোটউইড। এই গাছ থেকেই অদূর ভবিষ্যতে সস্তায় মিলবে ভায়াগ্রার বিকল্প ওষুধ। পুরুষাঙ্গকে দৃঢ়তা প্রদানের জন্য যে যৌগটি দরকার, সেই আইকারিন প্রচুর পরিমাণে রয়েছে হর্নি গোটউইডে।
এই উপদানটিকে প্রকৃতিক ভায়াগ্রা হিসেবে শনাক্ত করেছেন ইউনিভার্সিটি অফ মিলানের গবেষক ডা. মারিও ডেল...
চীনের একটি গাছের নাম হর্নি গোটউইড। এই গাছ থেকেই অদূর ভবিষ্যতে সস্তায় মিলবে ভায়াগ্রার বিকল্প ওষুধ। পুরুষাঙ্গকে দৃঢ়তা প্রদানের জন্য যে যৌগটি দরকার, সেই আইকারিন প্রচুর পরিমাণে রয়েছে হর্নি গোটউইডে।
এই উপদানটিকে প্রকৃতিক ভায়াগ্রা হিসেবে শনাক্ত করেছেন ইউনিভার্সিটি অফ মিলানের গবেষক ডা. মারিও ডেল...
 ব্রেন ক্যানসার চিকিৎসায় এবার ব্যবহৃত হবে সোনা৷ কারণ সোনা নাকি ব্রেন ক্যানসার থেকে মুক্তি দিতে পারে৷ বিজ্ঞান পত্রিকা ন্যানোস্কেল অনুযায়ী, ব্রেন ক্যানসারের চিকিৎসার সোনার একটি অতি সুক্ষ টুকরো সাহায্যকারী প্রমাণিত হতে পারে৷
বৈজ্ঞানিকরা একটি সোনার টুকরোকে গোলাকৃতি করে...
ব্রেন ক্যানসার চিকিৎসায় এবার ব্যবহৃত হবে সোনা৷ কারণ সোনা নাকি ব্রেন ক্যানসার থেকে মুক্তি দিতে পারে৷ বিজ্ঞান পত্রিকা ন্যানোস্কেল অনুযায়ী, ব্রেন ক্যানসারের চিকিৎসার সোনার একটি অতি সুক্ষ টুকরো সাহায্যকারী প্রমাণিত হতে পারে৷
বৈজ্ঞানিকরা একটি সোনার টুকরোকে গোলাকৃতি করে...
 বাতের ব্যথা, অনিদ্রা থেকে বার্ধক্যজনিত সমস্যা। এ সবের নিরাময়ে অশ্বগন্ধার বিকল্প নেই। তেমনটাই তো বলেন বিশেষজ্ঞরা। এমনকি যৌবন ধরে রাখতেও অশ্বগন্ধার উপকারিতা অনস্বীকার্য। ত্বকের সমস্যাতেও দারুণ কাজ দেয় অশ্বগন্ধার ভেষজ গুণ। বিদেশেও এর চাহিদা ব্যাপক। সে কারণেই অশ্বগন্ধা চাষ অত্যন্ত লাভজনক।...
বাতের ব্যথা, অনিদ্রা থেকে বার্ধক্যজনিত সমস্যা। এ সবের নিরাময়ে অশ্বগন্ধার বিকল্প নেই। তেমনটাই তো বলেন বিশেষজ্ঞরা। এমনকি যৌবন ধরে রাখতেও অশ্বগন্ধার উপকারিতা অনস্বীকার্য। ত্বকের সমস্যাতেও দারুণ কাজ দেয় অশ্বগন্ধার ভেষজ গুণ। বিদেশেও এর চাহিদা ব্যাপক। সে কারণেই অশ্বগন্ধা চাষ অত্যন্ত লাভজনক।...


.jpg&w=60&h=60&zc=2)
.jpg&w=60&h=60&zc=2)


.jpg&w=60&h=60&zc=2)


